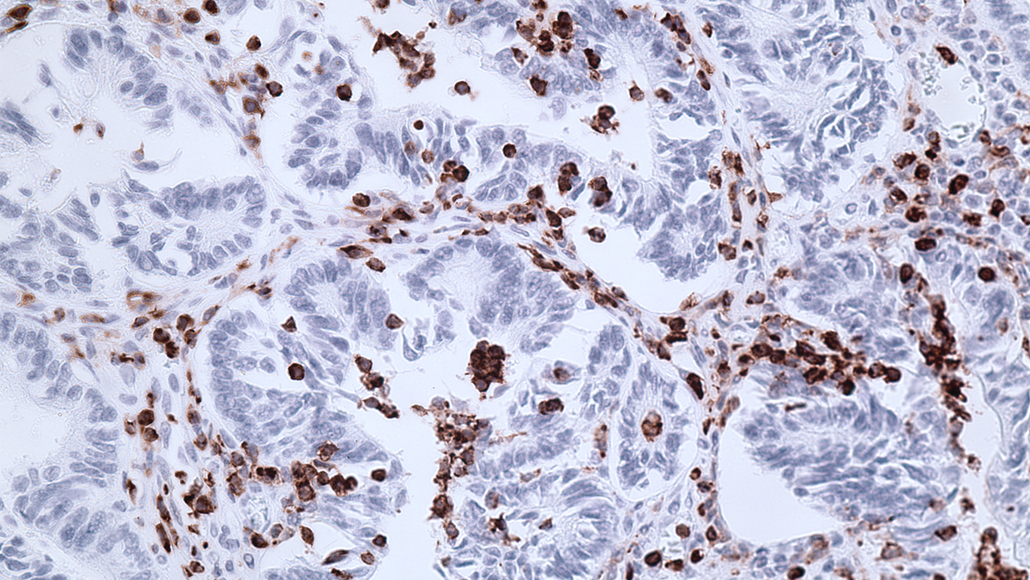
immune suppressor cells

These cells slow an immune response. Derailing them could help fight tumors
Drug combinations that release multiple brakes on the defense system curbed cancer in mice
Drugs that target immune suppressor cells (pictured as brown cells infiltrating the colon of a mouse with colorectal cancer) could help the body’s defense system fight cancer.
Woosook Kim